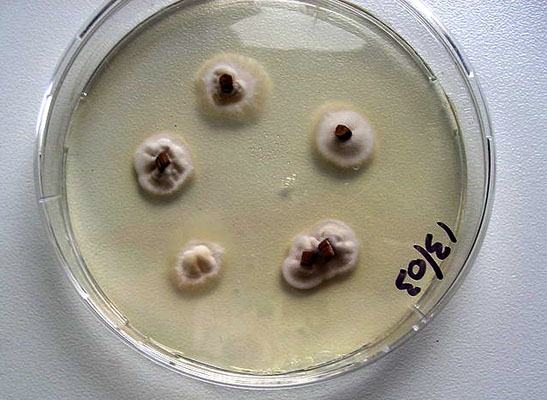

¿Qué es Claviceps purpurea?
Claviceps purpurea, conocido también como cornezuelo del centeno, es un hongo Ascomycota de la familia Clavicipitaceae, que parasita una gran variedad de cereales, principalmente el centeno. El cuerpo fructífero presenta un pie alargado que puede superar los 10 mm y una cabezuela de pocos mm marcada por unos ostiolos.
Es una especie venenosa que secreta una serie de sustancias que producen una gran variedad de afecciones en el cuerpo, incluyendo efectos vasoconstrictores en el sistema circulatorio y también influyendo en la transmisión de los impulsos nerviosos. Ejemplo de estas sustancias son la ergocristina, la ergometrina y la ergocriptina, entre otras.
La ingesta de alimentos elaborados con centeno contaminado por este hongo puede producir importantes trastornos a la salud, tanto en animales como en seres humanos, incluyendo la enfermedad conocida como ergotismo, fuego del infierno o fuego de San Antón.
Características de Claviceps purpurea
– Apariencia. Uno o varios cuerpos fructíferos pueden emerger de un solo esclerocio alargado, de color púrpura. Estos cuerpos fructíferos se presentan como unas setas miniaturas, con una forma que recuerda a la de pequeños clavos, con un pie delgado (4 o 5 mm), alargado (40 a 60 mm) y ligeramente curvado.
– Pie. El pie está rematado por una pequeña esfera a modo de cabeza de clavo, que presenta unos poros denominados ostiolos.
– Esporas. Son de forma muy alargada y poseen un espesor de 1 micrómetro.
Reproducción y ciclo de vida de Claviceps purpurea
Claviceps purpurea presenta en su ciclo de vida una fase de reproducción sexual y una asexual (anamórfica). La fase sexual se inicia con la germinación del esclerocio o cornezuelo. Este cornezuelo es una estructura de supervivencia que puede permanecer durante mucho tiempo en dormancia.
Generalmente, se requieren varias semanas de temperaturas ambientales frías para activar la germinación del cornezuelo, considerado como el inóculo primario de la enfermedad. Cuando las condiciones ambientales son adecuadas, se forma el esclerocio que puede producir uno o varios estromas.
Los estromas son estructuras somáticas de los hongos en las que se desarrollan las fructificaciones. En la parte inferior de las cabezuelas, se generan los gametangios masculinos y femeninos, y tras la reproducción sexual, se forman las hifas ascógenas, que posteriormente dan lugar a los peritecios.
En estos peritecios se encuentran los ascos o estructuras formadores de ascosporas. Las ascosporas se liberan al aire por medio de unos orificios en las cabezuelas, denominados ostiolos, y trasportadas por los vientos.
Solo aquellas ascosporas que alcancen el ovario del hospedador van a poder causar la infección. Estas ascosporas dan origen a los conidióforos.
Los conidios o esporas asexuales son haploides, unicelulares y elípticos y una vez producidos pueden dispersarse por insectos atraídos por un líquido dulce secretado por la planta infectada. Son los inóculos secundarios de la enfermedad.
Adicionalmente, las hifas del hongo se desarrollarán dando lugar a un nuevo esclerocio que eventualmente va a desprenderse al secarse la planta o al segar la espiga, y puede permanecer en estado de dormancia durante mucho tiempo en el suelo, para luego germinar cuando las condiciones sean apropiadas para iniciar un nuevo ciclo.
Hábitat y distribución de Claviceps purpurea
Claviceps purpurea es una especie parásita obligada, es decir, que siempre va a crecer parasitando a otra especie, principalmente el centeno y otros cereales. Habita sobre la planta y ataca el gineceo de su hospedador para formar el esclerocio.
Se encuentra ampliamente distribuida a nivel mundial, siendo reportado por los micólogos en todos los continentes.
Taxonomía de Claviceps purpurea
Claviceps purpurea es un hongo Ascomycota ubicado taxonómicamente dentro de la clase Sordariomycetes, orden Hypocreales y familia Clavicipitaceae. El género consta de más de 50 especies, todas ellas parásitas obligadas de una gran variedad de cereales y hierbas.
La especie fue descrita por el botánico suizo Elias Magnus Fries en 1823 con el nombre de Sphaeria purpurea.
Alcaloides producidos por Claviceps purpurea
El cornezuelo produce numerosos compuestos, entre ellos los más importantes son alcaloides del grupo ergolina, por ejemplo, la ergocristina, ergometrina, metilergonovina y la ergotamina.
Estos compuestos poseen un espectro de acción farmacológica muy complejo, incluyendo efectos vasoconstrictores del sistema circulatorio y efectos sobre la transmisión del impulso nervioso. Actúan sobre los receptores de dopamina y de serotonina.
Todos estos alcaloides derivan del compuesto conocido como tetracíclico 6-metilergolina, incluyendo el ácido lisérgico, precursor del LSD, un potente alucinógeno.
Además de los compuestos naturales producidos por el cornezuelo, se han obtenido numerosos derivados sintéticos mediante hidrogenación catalítica de los alcaloides naturales. Entre estos derivados sintéticos se encuentran, por ejemplo, dihidroergotamina, bromocriptina, dietilamida del ácido lisérgico y metisergida.
Enfermedades causadas por Claviceps purpurea
Los compuestos producidos por el cornezuelo tienen efectos graves sobre el organismo, entre ellos, los debidos a sus propiedades alucinógenas, que pueden conducir a estados de percepción alterados. Los investigadores han atribuido la actitud violenta y guerras de los vikingos a intoxicaciones por consumo de centeno infectado por el cornezuelo.
Los historiadores le atribuyen también los episodios de los famosos juicios a las brujas de Salem a intoxicaciones por consumo accidental de cornezuelo. Las intoxicaciones colectivas por consumo de pan de centeno contaminado eran frecuentes en la Edad Media.
- Ergotismo. Es la enfermedad más importante producida por el cornezuelo. Se conoce también como fuego del infierno o fuego de San Antón, y puede afectar tanto a seres humanos como a animales que ingieran centeno u otros cereales contaminados con Claviceps purpurea. Los primeros registros de esa enfermedad datan de hace más de 2.500 años y fueron encontrados en una tabla de arcilla asiria elaborada aproximadamente 600 años a.C. Durante la Edad Media, las intoxicaciones por cornezuelo eran tan frecuentes y comunes que podían ser consideradas epidemias y se crearon hospitales para la atención exclusiva de personas enfermas de ergotismo. Los frailes de la orden de san Antonio eran los encargados de atender estos hospitales. Los efectos del envenenamiento por ergotamina incluyen alucinaciones, convulsiones, contracción arterial, abortos en mujeres embarazadas, necrosis y gangrena a nivel de todos los miembros, que conllevaban la mutilación y generalmente a la muerte.
Usos médicos de Claviceps purpurea
A pesar de que la mayoría de los alcaloides producidos por el cornezuelo tienen efectos adversos sobre la salud, algunos productos, en cantidades apropiadas, se han utilizado con fines medicinales. Por ejemplo, los chinos lo empleaban para contraer el útero y evitar las hemorragias en el postparto.
Estas propiedades del cornezuelo no fueron aprovechadas en la medicina occidental hasta 1808, cuando el médico John Stearns llamó la atención de la comunidad médica sobre sus potencialidades para acelerar el parto y ahorrar mucho tiempo en el proceso.
Los investigadores también han probado medicamentos con base en estos alcaloides para tratar jaquecas, migrañas y algunos trastornos mentales.
Referencias
- Dewick, M. Medicinal Natural Products. A biosynthetic approach. John Wiley and Sons.
- Claviceps purpurea. Recuperado de en.wikipedia.org.
- Cornezuelo del centeno. Recuperado de apsnet.org.
- Claviceps purpurea. Recuperado de fungipedia.org.
- Alcaloides del cornezuelo de centeno. Recuperado de es.wikipedia.org.